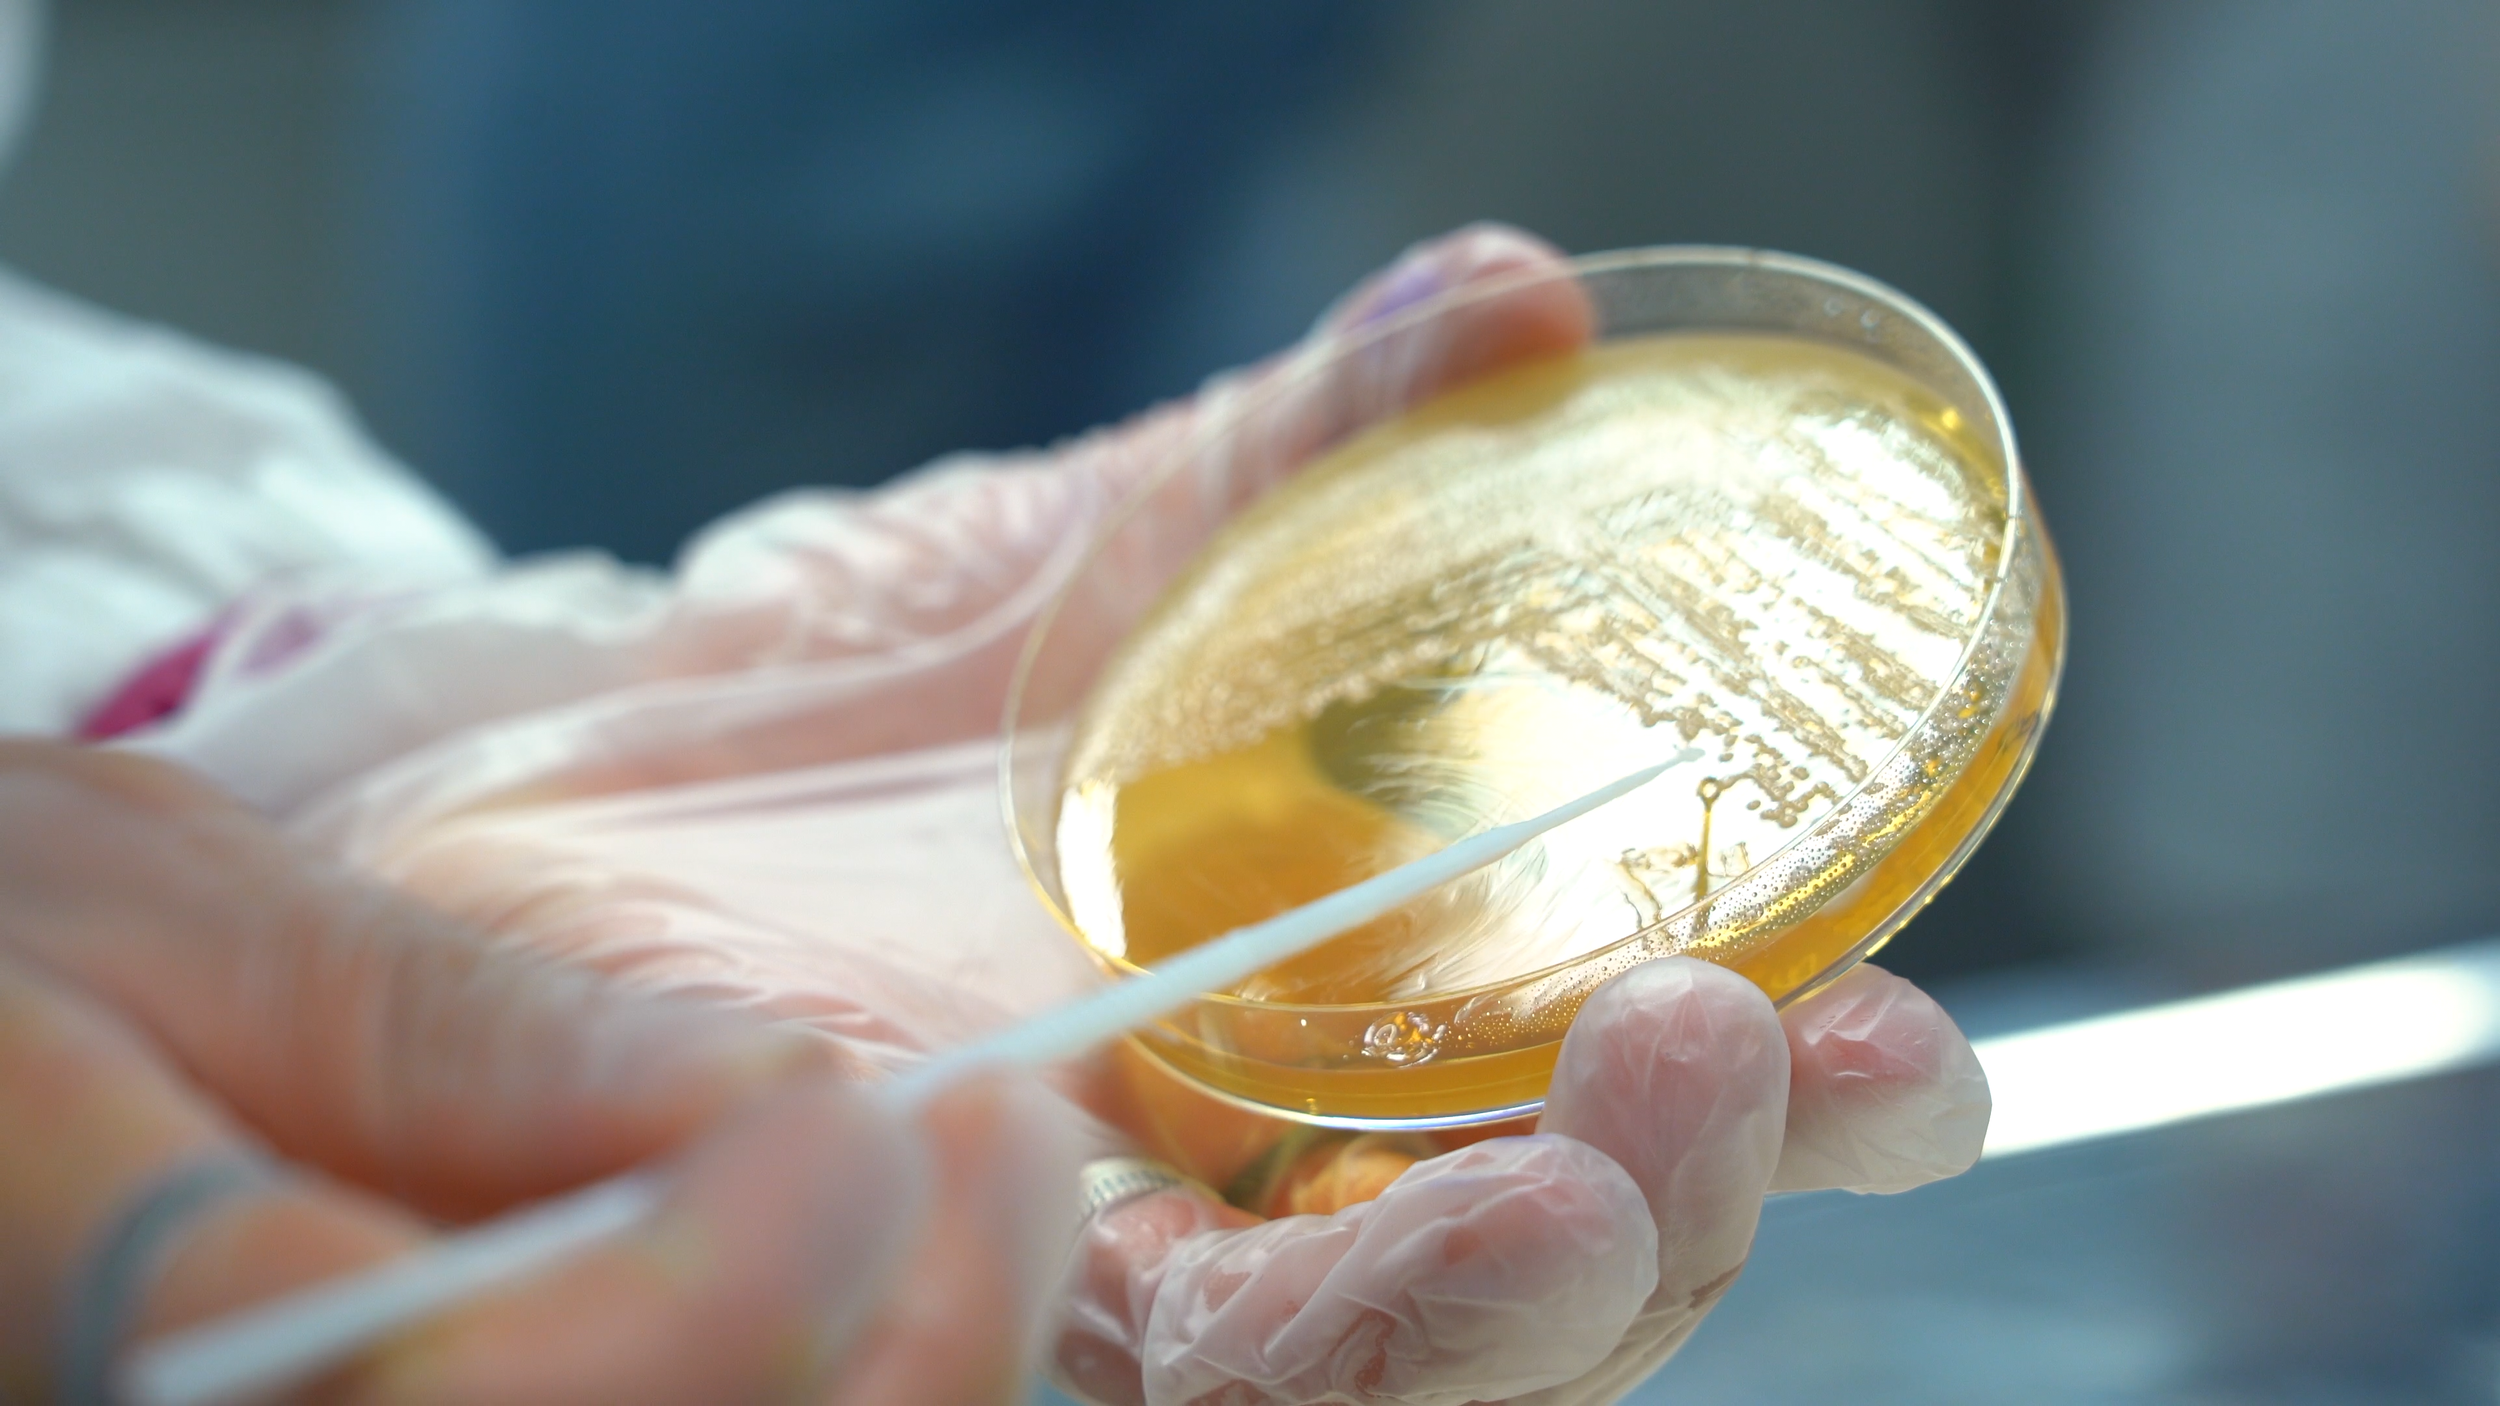

STAG
Scienze e tecnologie agrarie
2022
directed by: Alessandro Miolo
edited by: Alessandro Miolo
STAL
Scienze e tecnologie alimentari
2022
directed by: Alessandro Miolo
edited by: Alessandro Miolo
Animal Care
2021
directed by: Alessandro Miolo
edited by: Alessandro Miolo
STAN
Scienze e tecnologie animali
2021
directed by: Alessandro Miolo
edited by: Alessandro Miolo e Samuele Bogni
Tecnologie forestali e ambientali
2021
directed by: Alessandro Miolo
edited by: Alessandro Miolo e Samuele Bogni
SIA
Sicurezza igienico-sanitaria degli alimenti
2021
directed by: Alessandro Miolo
edited by: Alessandro Miolo e Samuele Bogni